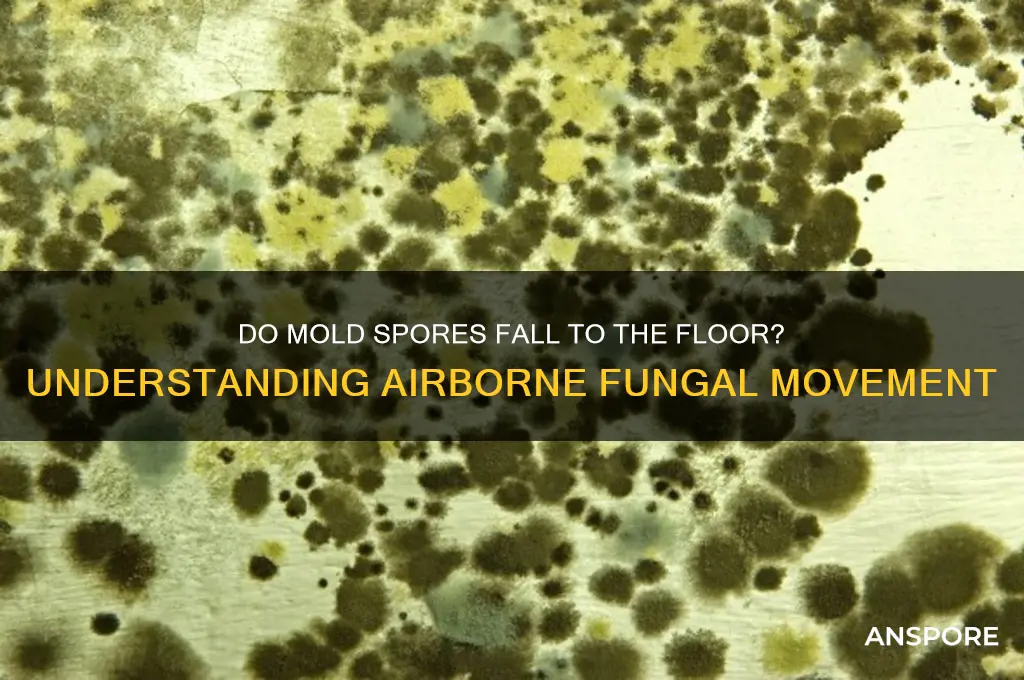
do mold spores fall to floor

Mold spores are microscopic particles that naturally exist in the air both indoors and outdoors, and they play a crucial role in the decomposition of organic matter. While mold spores are ubiquitous, their presence becomes a concern when they land on damp surfaces and begin to grow, potentially causing health issues and structural damage. A common question arises regarding whether mold spores fall to the floor, and the answer is yes—gravity causes many spores to settle on surfaces, including floors, over time. However, their lightweight nature allows them to remain suspended in the air for extended periods, circulating through ventilation systems or disturbances like cleaning or walking. Understanding how mold spores behave is essential for effective prevention and remediation, as controlling moisture and minimizing disturbances can reduce their accumulation on surfaces, including floors.
| Characteristics | Values |
|---|---|
| Do mold spores fall to the floor? | Yes, mold spores can settle on surfaces, including floors, due to gravity. |
| Size of mold spores | Typically 2-10 microns in diameter, small enough to remain airborne for extended periods but eventually settle. |
| Airborne behavior | Spores can remain suspended in air currents but will eventually fall due to gravity, especially in still air. |
| Settling time | Depends on spore size, air movement, and humidity; smaller spores may take longer to settle. |
| Floor accumulation | Spores can accumulate on floors, carpets, and other surfaces, especially in areas with poor ventilation. |
| Health implications | Settled spores on floors can be stirred back into the air by walking, vacuuming, or other disturbances, potentially causing respiratory issues. |
| Prevention | Regular cleaning, maintaining low humidity, and improving ventilation can reduce spore accumulation on floors. |
| Detection | Visible mold growth on floors or musty odors may indicate spore presence; testing can confirm spore levels. |
Explore related products
$13.48 $14.13
What You'll Learn

Gravity's Role in Spore Descent
Mold spores, microscopic and lightweight, are subject to the relentless pull of gravity. This fundamental force dictates their descent from airborne suspension to surfaces, including floors. Gravity acts as the primary driver, ensuring that spores, despite their size, eventually settle. Unlike larger particles, spores lack the mass to overcome gravitational pull for extended periods, making their descent inevitable. This process is not instantaneous; it depends on factors like spore size, air currents, and humidity, but gravity remains the constant factor.
Consider the mechanics of spore descent in a typical indoor environment. A mold spore, measuring between 3 to 40 micrometers, is released into the air. Its initial movement is influenced by air currents, but as these currents dissipate, gravity takes over. The spore’s terminal velocity—the maximum speed it reaches during descent—is extremely low due to its small size and air resistance. This slow descent allows spores to travel horizontally for short distances before settling. For example, in a room with minimal air movement, spores may take minutes to hours to reach the floor, depending on their size and height of release.
Practical implications of gravity-driven spore descent are significant for mold prevention. Since spores naturally fall, keeping floors clean is a critical step in mold control. Regular vacuuming with a HEPA filter can capture settled spores, preventing their germination. Additionally, reducing indoor humidity below 60% limits spore viability, as mold requires moisture to grow. For areas prone to mold, such as bathrooms or basements, using exhaust fans or dehumidifiers can disrupt spore settlement by maintaining air movement while still allowing gravity to pull spores downward.
Comparatively, gravity’s role in spore descent contrasts with the behavior of larger particles, like dust, which may settle more quickly due to greater mass. Spores’ lightweight nature allows them to remain suspended longer, but gravity ensures they eventually fall. This distinction highlights the importance of targeted cleaning strategies. While dusting surfaces addresses larger particles, addressing mold spores requires a focus on floors and lower surfaces where they accumulate. Understanding this difference can optimize cleaning routines for both particle types.
In conclusion, gravity is the silent orchestrator of spore descent, ensuring that mold spores, despite their microscopic size, inevitably fall to the floor. This process, influenced by spore size and environmental factors, underscores the importance of floor maintenance in mold prevention. By leveraging this knowledge, individuals can implement effective strategies, such as regular cleaning and humidity control, to mitigate mold growth. Gravity’s role, though often overlooked, is a cornerstone in the battle against mold proliferation.
Exploring the Possibility of Copying a Spore Creator: A Guide
You may want to see also

Air Currents vs. Floor Settling
Mold spores are microscopic and lightweight, allowing them to remain suspended in air currents for extended periods. These currents, driven by HVAC systems, fans, or even human movement, can transport spores throughout a space, delaying their descent to surfaces. For instance, a single spore can travel up to 100 meters in outdoor environments, and indoor air circulation can keep them aloft for hours or even days. This airborne phase is critical for mold proliferation, as spores seek out moisture-rich areas to colonize. Understanding this dynamic is essential for anyone aiming to control mold growth, as air filtration and ventilation play pivotal roles in reducing spore concentration.
To mitigate the spread of mold spores, consider these actionable steps: first, use HEPA filters in air purifiers or HVAC systems to capture spores before they settle. Second, maintain consistent airflow by keeping vents unobstructed and using fans strategically to direct air away from moisture-prone areas. Third, monitor humidity levels with a hygrometer, aiming for below 50% to discourage spore germination. For example, in a 1,500-square-foot home, a 200-CFM (cubic feet per minute) air purifier can effectively reduce airborne spores in a single room within 2 hours. These measures prioritize air management over surface cleaning, addressing the root of spore dispersal.
While air currents keep spores suspended, eventual settling on floors and surfaces is inevitable. Gravity and reduced air movement cause spores to accumulate in lower areas, particularly in carpet fibers, cracks, and under furniture. A study found that up to 70% of settled spores can remain viable for months, awaiting optimal conditions to grow. This highlights the importance of regular cleaning, especially in high-risk zones like basements or bathrooms. Vacuuming with a HEPA filter and mopping with a mild detergent can remove settled spores, but without addressing air circulation, the cycle repeats.
Comparing air currents to floor settling reveals a dual-pronged approach to mold control. Air currents are the highway for spore distribution, while floor settling marks the end of their journey—and potentially the beginning of colonization. For instance, in a mold-prone basement, spores may circulate via a window fan but eventually settle on damp cardboard boxes, leading to growth. By focusing on both airflow and surface hygiene, homeowners can disrupt this cycle. Practical tips include elevating furniture off the floor to reduce settling zones and using dehumidifiers to target moisture where spores land.
Persuasively, ignoring the interplay between air currents and floor settling is a recipe for recurring mold issues. Relying solely on surface cleaning overlooks the airborne phase, while neglecting floors allows settled spores to thrive. A holistic strategy combines air purification, humidity control, and regular cleaning to target spores at every stage. For example, a family with allergies might invest in a whole-house air purifier and commit to weekly vacuuming of high-traffic areas, reducing both airborne and settled spore exposure. This integrated approach not only prevents mold but also improves indoor air quality, benefiting overall health.
Troubleshooting Steam: Why Can't You Connect to Spore Servers?
You may want to see also

Spore Size and Falling Speed
Mold spores, ranging in size from 2 to 100 micrometers, are microscopic particles that defy intuition when it comes to their movement through air. Their settling speed, governed by Stokes’ law, depends on size and air resistance. A 10-micrometer spore, typical of many mold species, falls at approximately 0.01 meters per second in still air. This means it takes about 2.5 hours to descend one meter, assuming no air currents. In practical terms, spores remain suspended for extended periods, but they do eventually settle—often on floors, furniture, or other surfaces where they can germinate under favorable conditions.
Consider the implications for indoor environments. In a room with minimal air movement, spores released from a damp wall or ceiling will gradually drift downward, accumulating on surfaces over time. This is why mold remediation often involves cleaning floors and lower surfaces thoroughly. However, smaller spores (under 5 micrometers) may remain airborne for days, increasing the risk of inhalation. Larger spores, while settling faster, are less likely to be inhaled but more likely to colonize surfaces where moisture is present. Understanding these dynamics helps in targeting prevention and cleanup efforts effectively.
To minimize spore settling, control air movement strategically. Using HEPA filters removes spores from the air, while fans or HVAC systems can disrupt settling patterns. For example, directing airflow upward can prevent spores from accumulating on floors, but this must be balanced with avoiding spore redistribution. In mold-prone areas, such as basements or bathrooms, maintaining low humidity (below 50%) and promptly fixing leaks reduces spore germination risk. Regularly vacuuming with a HEPA-filtered device also prevents settled spores from becoming airborne again during cleaning.
Comparing mold spores to other airborne particles highlights their unique behavior. Pollen grains, often larger than 100 micrometers, settle much faster, while bacteria and viruses, typically under 5 micrometers, remain suspended indefinitely. Mold spores occupy a middle ground, combining slow settling with eventual surface colonization. This makes them particularly insidious in indoor spaces, where they can persist unnoticed until conditions allow for growth. Unlike allergens like dust mites, which cling to fabrics, mold spores are more likely to accumulate on hard surfaces, making floor cleaning a critical control measure.
In summary, spore size dictates falling speed, but environmental factors like air movement and humidity play decisive roles in their fate. Smaller spores linger in the air, posing respiratory risks, while larger ones settle more quickly, colonizing surfaces. Practical steps, such as using HEPA filters, controlling humidity, and strategic cleaning, can mitigate both risks. By understanding these dynamics, homeowners and professionals can more effectively prevent mold growth and protect indoor air quality.
Can You Smell Mold Spores? Uncovering the Truth Behind the Scent
You may want to see also
Explore related products

Surface Attraction Factors
Mold spores are ubiquitous in the environment, but their settlement on surfaces isn't random. Surface attraction factors play a critical role in determining where spores land and whether they colonize. One key factor is surface texture. Rough surfaces, such as untreated wood or porous concrete, provide more crevices for spores to adhere to, increasing the likelihood of colonization. Smooth, non-porous surfaces like glass or polished metal, on the other hand, offer fewer anchoring points, making it harder for spores to settle and grow. This principle is why mold is more commonly found on textured walls or grout lines rather than on sleek countertops.
Humidity and moisture levels are another critical surface attraction factor. Mold spores require moisture to germinate and thrive, so surfaces with higher humidity or frequent dampness are prime targets. For instance, bathroom tiles or basement floors are common mold hotspots due to their exposure to moisture. Even slight condensation on windowsills can attract spores, especially in cooler climates. To mitigate this, maintaining indoor humidity below 60% and promptly fixing leaks can significantly reduce spore attraction to these surfaces.
Electromagnetic charge also influences spore settlement. Mold spores can carry a slight negative charge, making them more likely to adhere to positively charged surfaces. This phenomenon is less controllable but highlights the complexity of spore behavior. For example, certain fabrics or carpets may accumulate more spores due to their electrostatic properties. Regular cleaning with microfiber cloths, which can attract and trap charged particles, can help minimize spore buildup on these surfaces.
Temperature gradients create microclimates that attract spores. Surfaces near heat sources, like radiators or vents, may experience warmer, drier conditions that discourage mold. Conversely, cooler surfaces, such as exterior walls or floors near uninsulated areas, can create pockets of moisture through condensation, making them more attractive to spores. Homeowners can address this by improving insulation and ensuring proper ventilation in temperature-sensitive areas.
Finally, organic matter on surfaces acts as a magnet for mold spores. Dust, skin cells, and food particles provide nutrients for spores to germinate. Regular cleaning with HEPA-filtered vacuums and damp mopping can remove these attractants, reducing the risk of mold growth. For high-risk areas like kitchens and bathrooms, using mold-inhibiting cleaners containing ingredients like tea tree oil or hydrogen peroxide can provide an additional layer of protection. Understanding these surface attraction factors empowers individuals to take proactive steps in preventing mold colonization.
Does Vinegar Effectively Kill Mold Spores? A Comprehensive Guide
You may want to see also

Time for Spores to Reach Floor
Mold spores, ever-present in the air, are in a constant state of descent, but the time it takes for them to reach the floor is a fascinating interplay of physics and environmental factors. These microscopic particles, typically ranging from 2 to 100 micrometers in size, are subject to gravitational pull, yet their journey is influenced by air currents, humidity, and even the presence of other particles. For instance, a spore’s settling velocity, calculated using Stokes' law, depends on its size and density, with larger spores falling faster. In a still room, a 10-micrometer spore might take just a few minutes to descend from a height of 2 meters, while smaller spores could remain suspended for hours or even days.
Consider a practical scenario: a home with poor ventilation and high humidity. Here, mold spores not only settle more slowly due to increased air resistance but also find a conducive environment to thrive once they land. In contrast, a well-ventilated space with air movement accelerates the descent of spores, potentially reducing their airborne concentration but increasing the likelihood of them accumulating on surfaces. For homeowners, this means that regular dusting and vacuuming with a HEPA filter can significantly mitigate spore buildup, especially in areas prone to moisture, like bathrooms and basements.
From a comparative standpoint, the time for spores to reach the floor varies dramatically between indoor and outdoor environments. Outdoors, wind and temperature gradients create turbulent air flows that keep spores suspended longer, often redistributing them rather than allowing them to settle. Indoors, however, the absence of such turbulence means spores follow a more predictable path downward. This distinction highlights why indoor mold issues are often more persistent—spores have a higher chance of landing and colonizing surfaces in the absence of disruptive forces.
To minimize the time spores remain airborne and their chances of settling, proactive measures are key. Using air purifiers with HEPA filters can capture spores before they descend, while maintaining indoor humidity below 50% discourages mold growth. For those with allergies or respiratory sensitivities, understanding this settling time underscores the importance of regular cleaning routines. For example, wiping surfaces with a damp cloth instead of dry dusting prevents spores from becoming airborne again, effectively breaking the cycle of spore circulation.
In conclusion, the time it takes for mold spores to reach the floor is not a fixed duration but a dynamic process influenced by size, environment, and human intervention. By manipulating these factors—through ventilation, humidity control, and air filtration—individuals can significantly reduce spore settlement and the associated risks of mold growth. This knowledge transforms passive observation into active prevention, making it a critical tool for maintaining healthy indoor spaces.
Can Your Body Naturally Combat Tetanus Spores? Unveiling the Truth
You may want to see also
Frequently asked questions
Yes, mold spores can fall to the floor due to gravity, especially when disturbed or when air circulation is minimal.
Mold spores can remain airborne for hours, days, or even longer, depending on factors like humidity, air movement, and particle size, but eventually, many will settle on surfaces, including the floor.
Yes, mold spores on the floor can become airborne again when disturbed by activities like walking, vacuuming, or cleaning, unless proper precautions are taken.































